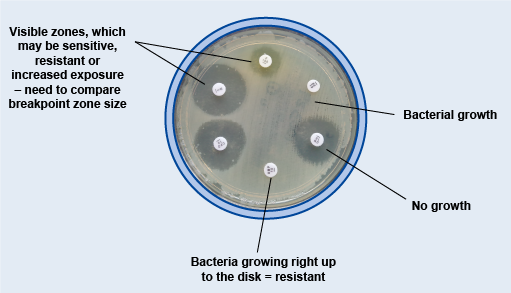
Described image

3.3 Measuring and interpreting the test
After incubation, the zone sizes are measured and interpreted. The size of the zone of inhibition depends on the MIC of the antibiotic for the strain being tested, and the size of the antibiotic molecules.
Does a bigger inhibition zone mean that an organism is more susceptible, or the antibiotic more potent?
Small antibiotic molecules diffuse further in the agar and, for susceptible organisms, will result in bigger inhibition zones. However, this does not mean that the organism is more susceptible or the antibiotic is more potent. An antibiotic with a larger molecular size could have a relatively small inhibition zone even if the organism is susceptible.
Therefore, direct comparisons cannot be made between zone sizes for different antibiotics. The inhibition zone for a given pathogen-antibiotic combination must be compared with a reference standard.
It is also important to note that the zone size does not give the exact MIC: if it is important to know this, then a dilution method or Etest should be used (see Section 4).
Just like the previous steps of the disk diffusion test, EUCAST and the CLSI recommend international standards for measuring and interpreting disk diffusion test results. The measured zone size should be compared against the zone sizes given by whichever method has been used to set up the tests to decide whether the isolate is susceptible or resistant (see Figure 6). Remember that for diagnosis of illness in animals, CLSI VET guidelines should be used. The VET tables include antibiotics that are not used for treatment in humans, but overall there are far fewer breakpoints available.
Video 4 describes stages 4 and 5 of the recommended standards for reading disk diffusion tests:
If you are unable to watch Video 4, slides 22 onwards of EUCAST’s disk diffusion method slidecast [Tip: hold Ctrl and click a link to open it in a new tab. (Hide tip)] cover the same material (EUCAST, 2025a).
Do not worry if you are not familiar with the terms ‘swarming’ and ‘haemolysis’ that are mentioned in the video and slidecast – different pathogens may behave somewhat differently in the disk diffusion test, but for this course you are only concerned with the basic principles of measuring zones of inhibition.
As with the previous steps of the disk diffusion test, the exact way that zones of inhibition are measured can depend on the pathogen-antibiotic combination. Your workplace’s SOP should describe in detail how to measure the zone of inhibition for the pathogen-antibiotic combinations that you are working with. If it does not, then refer to the EUCAST guidelines.
Once the diameter of the zone of inhibition has been measured, the results need to be interpreted to determine whether the microorganism is susceptible or resistant to the antibiotic. This is done using zone diameter breakpoint tables.
As for the MIC breakpoints you looked at in Section 1.1, if a zone diameter measurement falls between the susceptible (S) and resistant (R) zone diameter breakpoint given in the breakpoint table, then the result is interpreted as susceptible to increased exposure to the antibiotic (I).
You can practise using breakpoint tables in Activity 4. Select the clinical or veterinary option to access appropriate data.
Activity 4a: Using breakpoint tables (clinical data option)
Table 1 shows a breakpoint table for Enterobacterales (known until recently as ‘Enterobacteriaceae’) and cephalosporin antibiotics.
| Enterobacterales | Zone diameter breakpoints (mm) | |
|---|---|---|
| Susceptible (S) ≥ | Resistant (R) < | |
| Cefepime | 27 | 24 |
| Cefotaxime | 20 | 17 |
| Ceftobiprole | 23 | 23 |
| Ceftazidime | 22 | 19 |
| Ceftaroline | 23 | 23 |
You have measured the cefepime zone of inhibition for E. coli (an Enterobacterales) as 20 mm. Using Table 1, would you interpret this result as S, R or I?
Answer
Using Table 1, this result would be interpreted as R (resistant) because the zone diameter is smaller than 24 mm.
Activity 4b: Using breakpoint tables (veterinary data option)
Table 2 shows a breakpoint table for Enterobacterales and fluoroquinolone antibiotics.
| Antibiotic | Animal species | Zone diameter breakpoint (mm) and interpretation | |
|---|---|---|---|
| Susceptible (S) ≥ | Resistance (R) ≤ | ||
| Enrofloxacin | Dog | 23 | 16 |
| Cat | 23 | 16 | |
| Marbofloxacin | Dog | 20 | 14 |
| Cat | 20 | 14 | |
| Orbifloxacin | Dog | 23 | 17 |
| Cat | 23 | 17 | |
You have measured the orbifloxacin zone of inhibition for a Salmonella typhimurium (an Enterobacterales) isolate from a cat as 16 mm. Using Table 2, would you interpret this result as S, R or I?
Answer
Using Table 2, this result would be interpreted as R (resistant) because the zone diameter is smaller than 17 mm.
Activity 5: Measuring and interpreting a disk diffusion test
In this activity you will measure the zones of inhibition in a disk diffusion test and then use breakpoint tables to interpret these measurements.
Part 1
Follow the link below to access an interactive version of a measurement tool that you can use to measure the zone of inhibition for each disk on a petri dish. Record your measurements in millimetres.
(If you are unable to access the interactive tool, you can use a non-interactive version of this activity.)
Part 2
Table 3 shows the zone of inhibition measurements made by a random sample of people.
- How do your measurements compare?
- What might account for any differences between observers?
- How might you minimise any differences?
| Student | Zone measurement (mm) | ||||
|---|---|---|---|---|---|
| Meropenem (MEM) | Piperacillin/ tazobactam (TZP) | Amikacin (AK) | Augmentin (AUG) | Cefopodoxime/ clavulanic acid (CD) | |
| A | 13 | 1 | 6 | 1 | 0 |
| B | 30 | 8 | 20 | 6 | 0 |
| C | 32 | 9 | 20 | 9 | 0 |
| D | 32 | 8 | 19 | 7 | 0 |
| E | 33 | 9 | 21 | 8 | 0 |
| F | 20 | 8 | 19 | 6 | 0 |
Answer
- As with most scientific data, there is usually some minor variability in the measurements that people make.
- If the zone of inhibition is not perfectly circular, then people may have used different criteria to determine where the edge of the zone was. For example, the zone edge may not be a clear-cut line but rather a hazy margin, or there could be scattered colonies inside the zone or the appearance of a double margin. These differences need to be looked at in a standardised way.
- This could be done by including details in the SOP of how to measure zones of inhibition, including how to define the edge of a zone and where to measure the diameter. Staff training and other quality control measures are also important. You will learn more about this in the Quality assurance and AMR surveillance course.
Part 3
Now look at the following excerpt from the EUCAST breakpoint table for Enterobacterales and use the measurements that you collected in the first part of this activity to determine whether this bacterial isolate is susceptible or resistant to each antibiotic in the disk diffusion test.
Finally, check your zone diameter measurements and susceptibility/resistant rating for each antibiotic against the standard answer.
| Antibiotic | Zone diameter breakpoint (mm) | |
|---|---|---|
| S ≥ | R < | |
| Meropenem (MEM) | 22 | 16 |
| Piperacillin/tazobactam (TZP) | 20 | 17 |
| Amikacin (AK) | 18 | 18 |
| Co-amoxiclav (AUG) | 19 | 19 |
| Cefpodoxime/clavulanic acid (CD) | n.d. | n.d. |
Footnotes
n.d. = not yet establishedAnswer
| Antibiotic | Sample measured zone diameter (mm) | Susceptibility |
|---|---|---|
| Meropenem (MEM) | 32 | S |
| Piperacillin/tazobactam (TZP) | 8 | R |
| Amikacin (AK) | 19 | S |
| Co-amoxiclav (AUG) | 7 | R |
| Cefpodoxime/clavulanic acid (CD) | 7 | n.d. |
Footnotes
n.d. = not yet establishedPart 4
If you have access to a disk diffusion test from your own workplace, you might like to repeat this activity. You can find breakpoint tables for other pathogens on the EUCAST website.
3.2 Setting up the test